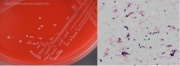

העלאות של Motyk
מתוך ויקירפואה
דף מיוחד זה מציג את כל הקבצים שהועלו.
| תאריך | שם | תמונה ממוזערת | גודל | תיאור | גרסאות |
|---|---|---|---|---|---|
| 14:06, 29 באוגוסט 2021 | CGRP1.jpg (קובץ) |  |
278 קילו־בייטים | 1 | |
| 15:23, 16 באוגוסט 2021 | TRP-3.png (קובץ) |  |
315 קילו־בייטים | 1 | |
| 15:09, 16 באוגוסט 2021 | TRP-2.gif (קובץ) |  |
3 קילו־בייטים | 1 | |
| 14:30, 16 באוגוסט 2021 | TRP-1.png (קובץ) |  |
607 קילו־בייטים | 1 | |
| 11:17, 13 באוגוסט 2021 | CoA -2.jpg (קובץ) |  |
67 קילו־בייטים | 1 | |
| 11:17, 13 באוגוסט 2021 | CoA -1.jpg (קובץ) |  |
88 קילו־בייטים | 1 | |
| 09:35, 4 באוגוסט 2021 | Risankizumab-1.png (קובץ) |  |
34 קילו־בייטים | 1 | |
| 07:50, 2 באוגוסט 2021 | 3-Fibulin-2.PNG (קובץ) |  |
13 קילו־בייטים | 2 | |
| 13:22, 1 באוגוסט 2021 | Fibulin3-1.jpg (קובץ) |  |
43 קילו־בייטים | 1 | |
| 16:39, 25 ביולי 2021 | TGFβ 1.png (קובץ) |  |
117 קילו־בייטים | 1 | |
| 18:17, 20 ביולי 2021 | Plasmalogen1.png (קובץ) |  |
82 קילו־בייטים | 1 | |
| 09:35, 5 ביולי 2021 | FGF23-2.jpg (קובץ) | שגיאה ביצירת תמונה ממוזערת: קובץ חסר |
143 קילו־בייטים | 1 | |
| 09:04, 5 ביולי 2021 | FGF23-1.jpg (קובץ) | שגיאה ביצירת תמונה ממוזערת: קובץ חסר |
100 קילו־בייטים | 1 | |
| 07:28, 14 ביוני 2021 | AK-1.jpg (קובץ) | שגיאה ביצירת תמונה ממוזערת: קובץ חסר |
180 קילו־בייטים | 1 | |
| 06:10, 14 ביוני 2021 | קהילה1.png (קובץ) | שגיאה ביצירת תמונה ממוזערת: קובץ חסר |
195 קילו־בייטים | 1 | |
| 10:03, 24 במאי 2021 | Mannosidosis 2.png (קובץ) |  |
190 קילו־בייטים | 1 | |
| 09:52, 24 במאי 2021 | Mannosidosis 1.jpg (קובץ) |  |
43 קילו־בייטים | 1 | |
| 11:17, 2 במאי 2021 | ICG 2.jpg (קובץ) |  |
19 קילו־בייטים | 1 | |
| 11:11, 2 במאי 2021 | ICG 1.png (קובץ) |  |
24 קילו־בייטים | 1 | |
| 09:52, 28 באפריל 2021 | טלאנגיאקטזיה1.png (קובץ) |  |
880 קילו־בייטים | 1 | |
| 09:49, 28 באפריל 2021 | טלאנגיאקטזיה.png (קובץ) |  |
135 קילו־בייטים | 1 | |
| 09:47, 28 באפריל 2021 | Sclerodactyly3.jpg (קובץ) |  |
12 קילו־בייטים | 1 | |
| 09:45, 28 באפריל 2021 | Sclerodactyly2.jpg (קובץ) |  |
9 קילו־בייטים | 1 | |
| 09:43, 28 באפריל 2021 | Sclerodactyly1.jpg (קובץ) |  |
95 קילו־בייטים | 1 | |
| 08:03, 28 באפריל 2021 | Galanin1.jpg (קובץ) |  |
127 קילו־בייטים | 1 | |
| 18:29, 18 באפריל 2021 | Enkephalin2.png (קובץ) |  |
1.76 מגה־בייטים | 1 | |
| 18:19, 18 באפריל 2021 | Enkphalin1.png (קובץ) |  |
317 קילו־בייטים | 1 | |
| 06:22, 18 באפריל 2021 | היפרליפידמיה3.png (קובץ) |  |
63 קילו־בייטים | 2 | |
| 05:00, 13 באפריל 2021 | Comt1.png (קובץ) |  |
107 קילו־בייטים | 1 | |
| 05:27, 31 במרץ 2021 | Α-synuclein1.png (קובץ) |  |
369 קילו־בייטים | 1 | |
| 08:01, 24 בפברואר 2021 | כאב ביילוד3.jpg (קובץ) |  |
30 קילו־בייטים | 1 | |
| 08:00, 24 בפברואר 2021 | כאב ביילוד2.jpg (קובץ) |  |
21 קילו־בייטים | 1 | |
| 08:00, 24 בפברואר 2021 | כאב ביילוד1.jpg (קובץ) |  |
22 קילו־בייטים | 1 | |
| 11:14, 22 בפברואר 2021 | SCORAD3.png (קובץ) |  |
143 קילו־בייטים | 1 | |
| 06:43, 22 בפברואר 2021 | SCORAD2.png (קובץ) | 13 קילו־בייטים | 1 | ||
| 06:29, 22 בפברואר 2021 | SCORAD1.jpg (קובץ) |  |
39 קילו־בייטים | 1 | |
| 19:19, 21 בפברואר 2021 | סולם אטופי.jpg (קובץ) |  |
50 קילו־בייטים | 1 | |
| 16:29, 18 בפברואר 2021 | WET WRAP2.jpg (קובץ) |  |
36 קילו־בייטים | 1 | |
| 16:29, 18 בפברואר 2021 | WET WRAP1.jpg (קובץ) |  |
41 קילו־בייטים | 1 | |
| 07:11, 12 בפברואר 2021 | Venetoclax-2.png (קובץ) |  |
39 קילו־בייטים | 1 | |
| 07:09, 12 בפברואר 2021 | Venetoclax-1.png (קובץ) |  |
108 קילו־בייטים | 1 | |
| 07:05, 12 בפברואר 2021 | Gemtozumab ozogamicin-1.png (קובץ) |  |
42 קילו־בייטים | 1 | |
| 07:01, 12 בפברואר 2021 | Gilteritinib-1.png (קובץ) |  |
36 קילו־בייטים | 1 | |
| 06:44, 12 בפברואר 2021 | Midostaurin-1.png (קובץ) |  |
17 קילו־בייטים | 1 | |
| 13:55, 7 בפברואר 2021 | GBS-1.jpg (קובץ) | |
21 קילו־בייטים | 1 | |
| 13:15, 3 בפברואר 2021 | FoundationOne-2.png (קובץ) |  |
120 קילו־בייטים | 1 | |
| 15:14, 27 בינואר 2021 | Dyslipidemia-1.png (קובץ) |  |
329 קילו־בייטים | 1 | |
| 14:52, 27 בינואר 2021 | Dyslipidemia.png (קובץ) |  |
844 קילו־בייטים | 2 | |
| 14:05, 26 בינואר 2021 | KRAS-5.jpg (קובץ) |  |
30 קילו־בייטים | 1 | |
| 14:03, 26 בינואר 2021 | KRAS-4.png (קובץ) |  |
947 קילו־בייטים | 1 |


 כניסה
כניסה  עקבו אחרינו בפייסבוק
עקבו אחרינו בפייסבוק